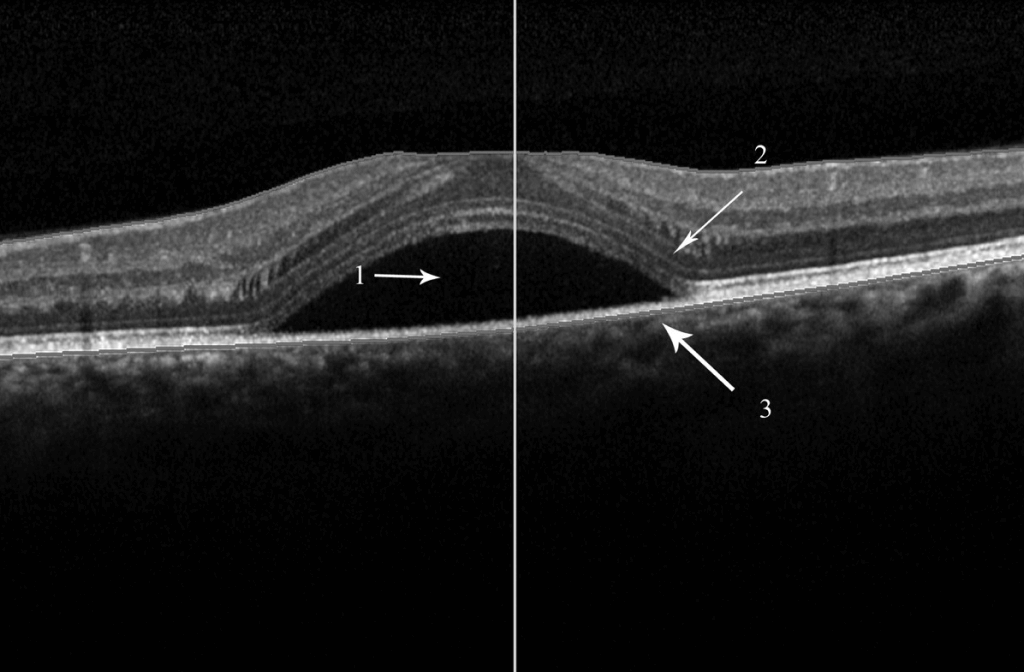

Sight - Your Most Important Sense.
Don't Lose It!
Holistic eye treatment with high success rate and backed by scientific and biomedical research studies.
CONDITIONS TREATEDScroll Down


SEVEN DAY GUARANTEE
Patients see vision improvements in just 7 days of treatment.
Netra Vision Improvement Guarantee Program is a full money back guarantee on your treatment.
Our guarantee reflects both our confidence and our proven success rate.
Appointments/Inquiries
HEAR PATIENTS SAY
Glaucoma & High Myopia -Vision Improved
Maria
Keratoconus and Myopia - Vision Restored
Veeral
PATIENTS FEEDBACK
Appointments/Inquiries
CONDITIONS TREATED

Glaucoma

Macular Degeneration

Diabetic Retinopathy

Myopia

Dry Eyes
Central Serous Retinopathy
COMPLETE LIST
• Age-Related Macular Degeneration (ARMD)
• AMPPE
• Astigmatism
• Central Serous Retinopathy (CSR)
• Corneal Dystrophy
• Cystoid Macular Edema (CME)
• Diabetic Retinopathy
• Diabetic Macular Edema
• Dry Eyes
• Fuchs’ Dystrophy
• Glaucoma
• Keratoconus
• Macular Edema
• AMPPE
• Astigmatism
• Central Serous Retinopathy (CSR)
• Corneal Dystrophy
• Cystoid Macular Edema (CME)
• Diabetic Retinopathy
• Diabetic Macular Edema
• Dry Eyes
• Fuchs’ Dystrophy
• Glaucoma
• Keratoconus
• Macular Edema
• Macular Dystrophy
• Macular Hole
• Macular Pucker
• Macular Telangatasia
• Myopia - Simple and Pathological
• Presbyopia
• Ptosis (Droopy Eyelid)
• Retinal Vein Occlusion (CRVO/BRVO)
• Retinitis Pigmentosa
• Retinoschisis
• Stargardt Disease
• Usher Syndrome
• Uveitis / Panuveitis / Keratitis
• White Dot Syndromes
• Macular Hole
• Macular Pucker
• Macular Telangatasia
• Myopia - Simple and Pathological
• Presbyopia
• Ptosis (Droopy Eyelid)
• Retinal Vein Occlusion (CRVO/BRVO)
• Retinitis Pigmentosa
• Retinoschisis
• Stargardt Disease
• Usher Syndrome
• Uveitis / Panuveitis / Keratitis
• White Dot Syndromes
ABOUT NETRA

Netra Eye Institute is the only clinic that offers holistic eye treatments combining Acupuncture, Chinese Herbal Medicine, and Ayurveda to address most chronic eye diseases.
We are proud to be the only holistic eye clinic in the USA that has shown to offers guaranteed results within 7 days of treatment.
Our signature Netra Restoration Therapy is a unique treatment method available exclusively at Netra Eye Institute, which has been shown to halt disease progression and improve vision.
We are proud to be the only holistic eye clinic in the USA that has shown to offers guaranteed results within 7 days of treatment.
Our signature Netra Restoration Therapy is a unique treatment method available exclusively at Netra Eye Institute, which has been shown to halt disease progression and improve vision.
Appointments/Inquiries
TREATMENT APPROACH
Our signature Netra Restoration Therapy is a unique treatment method available exclusively at Netra Eye Institute, which has been shown to halt disease progression and improve vision.
The Mechanism of Action (MOA) of Netra Restoration Therapy works by enhancing ocular blood flow through the regulation of vascular function, increasing neurotrophin levels and neuroprotection, and reducing ferroptosis, oxidative stress and ocular inflammation.
This, in turn, supports healthy circulation in the eyes, protects nerve cells, and minimizes harmful processes such as stress-related damage, inflammation, and toxic overload.”
The Mechanism of Action (MOA) of Netra Restoration Therapy works by enhancing ocular blood flow through the regulation of vascular function, increasing neurotrophin levels and neuroprotection, and reducing ferroptosis, oxidative stress and ocular inflammation.
This, in turn, supports healthy circulation in the eyes, protects nerve cells, and minimizes harmful processes such as stress-related damage, inflammation, and toxic overload.”
Vascular Dysregulation
Blood Flow Problems
Your eyes need a steady supply of blood to stay healthy. When the tiny vessels that feed the eye don’t regulate blood flow properly, some areas get too little oxygen while others get stressed by sudden changes.
This poor circulation can harm the optic nerve and retina, leading to conditions such as glaucoma or diabetic eye disease. Helping the blood vessels relax and keep a stable flow is key to protecting eyesight.
This poor circulation can harm the optic nerve and retina, leading to conditions such as glaucoma or diabetic eye disease. Helping the blood vessels relax and keep a stable flow is key to protecting eyesight.
Treament Benefits
- Improving circulation – Herbs like Ginkgo biloba and Danshen improve microcirculation and stabilize blood flow to the retina and optic nerve.
- Relaxing vessels – Natural compounds (e.g., flavonoids, nitric oxide boosters from beets) help blood vessels dilate and reduce spasm.
- Strengthening vessel walls – Bilberry, hawthorn, and vitamin C support vessel elasticity, lowering leakage and fragility.
- Reducing clotting risk – Some botanicals mildly balance platelets and improve flow, reducing ischemia.
- Balancing pressure and flow – Lifestyle practices (yoga breathing, stress reduction, acupuncture) help keep ocular perfusion stable.

Neurotrophin Deprivation
Loss of Nerve Growth Support
Just like plants need nutrients to grow, the nerve cells in the eye need “growth factors” to survive. When these support signals are cut off or reduced, the nerves begin to weaken and die, which can lead to vision loss.
Replacing or boosting these natural factors helps keep the nerves alive and working.
Replacing or boosting these natural factors helps keep the nerves alive and working.
Treament Benefits
- Stimulating natural growth factors – Many compounds found in herbal medicines enhance NGF and BDNF production.
- Supporting nerve repair – Omega-3 fatty acids (from flax, chia, fish oils) rebuild nerve membranes.
- Protecting mitochondria – Herbal antioxidants support the cell’s energy system.
- Reducing toxins – Herbal detox agents lower systemic oxidative burden that blocks growth factors.
- Holistic nourishment – Balanced diet, meditation, and adequate sleep restore the body’s natural nerve-healing signals.

Neuroprotection
Nerve damage and protection
In many eye diseases, the nerve cells are damaged by stress, toxins, or lack of energy. Even if the main cause (like high eye pressure) is treated, the damage may continue unless the nerve cells themselves are protected.
Treatments that calm down overactive signals, protect the cell’s “powerhouses” (mitochondria), or stop cell death can help slow or prevent further vision loss.
Treatments that calm down overactive signals, protect the cell’s “powerhouses” (mitochondria), or stop cell death can help slow or prevent further vision loss.
Treament Benefits
- Blocking excitotoxic signals – GABA boosters found in herbs shown to reduce nerve overstimulation.
- Preserving mitochondria – Polyphenols found in herbs shield the nerve’s power plants.
- Reducing cell death pathways – Antioxidant herbs such as saffron, and ginseng calm damaging signals.
- Providing anti-apoptotic support – Certain adaptogens found in herbs such as Rhodiola and Astragalus boost survival proteins in neurons.
- Stress reduction – Meditation, acupuncture, and mind-body medicine reduce stress hormones that worsen nerve death.

Cytokine Dysregulation
Immune System Imbalance
The immune system releases chemical messengers (called cytokines) that control inflammation. When this system is out of balance, the eye can swell, leak fluid, or scar.
Treatments that restore the balance of these messengers help calm the eye and protect delicate tissues.
Treatments that restore the balance of these messengers help calm the eye and protect delicate tissues.
Treament Benefits
- Balancing cytokines – Herbs such as Astragalus and turmeric regulate immune messengers, reducing overdrive.
- Soothing inflammation – Anti-inflammatory herbs (boswellia, chrysanthemum) calm irritated tissues.
- Restoring harmony – Adaptogenic herbs help balance Th1/Th2 immune responses.
- Reducing edema – Natural diuretics (nettle, parsley) may reduce swelling linked to cytokines.
- Gut-eye axis support – Probiotics and diet corrections rebalance systemic immunity, lowering cytokine surges.

Ocular Inflammation
Eye Inflammation
Sometimes the eye’s own defense system goes into overdrive. Inflammation can cause redness, swelling, pain, or damage inside the eye. If it lingers, it may lead to scarring or cloudy vision.
Controlling inflammation early helps save vision and gives the eye a chance to heal properly.
Controlling inflammation early helps save vision and gives the eye a chance to heal properly.
Treament Benefits
- Herbal anti-inflammatories – Curcumin, saffron, chrysanthemum lower inflammatory enzymes.
- Cooling and soothing – Topical compresses (rose water, chamomile) calm irritated eyes.
- Reducing immune triggers – Herbal blends that stabilize mast cells reduce allergic eye inflammation.
- Protecting delicate tissues – Antioxidants reduce collateral damage from immune cells.
- Lifestyle measures – Stress management, yoga, and anti-inflammatory diets reduce systemic inflammation that spills into the eyes.

Oxidative Stress
Free Radical Damage
The eye uses a lot of energy and is exposed to light every day, which makes it vulnerable to “rusting” damage caused by unstable molecules called free radicals.
This oxidative stress can wear down cells in the retina and optic nerve over time, contributing to diseases like glaucoma or macular degeneration.
Antioxidants from our treatment help neutralize this damage and protect vision.
This oxidative stress can wear down cells in the retina and optic nerve over time, contributing to diseases like glaucoma or macular degeneration.
Antioxidants from our treatment help neutralize this damage and protect vision.
Treament Benefits
- Neutralizing free radicals – Herbal antioxidants (saffron, green tea, resveratrol, lutein, zeaxanthin) mop up oxidative molecules.
- Supporting detox systems – Milk thistle, N-acetyl cysteine, and broccoli sprouts boost glutathione.
- Protecting mitochondria – CoQ10 and ginseng preserve energy production in eye cells.
- Light protection – Carotenoids (lutein, astaxanthin) filter harmful blue light, lowering oxidative stress.
- Diet and lifestyle – Plant-rich diet, regular exercise, and breathwork increase antioxidant reserves naturally.

Ferroptosis
Iron-Driven Cell Death
Scientists recently discovered a special type of cell damage in the eye caused by too much iron and harmful fats in the cells. This process, called ferroptosis, can kill nerve and retinal cells in conditions like glaucoma, macular degeneration and other eye disorders.
Protecting the eye from this iron-driven damage may become an important way to stop vision loss in the future.
Protecting the eye from this iron-driven damage may become an important way to stop vision loss in the future.
Treament Benefits
- Balancing iron levels – Herbs like green tea polyphenols and curcumin chelate excess iron.
- Boosting glutathione – Nutrients from garlic, onions, and cruciferous vegetables restore glutathione, a key ferroptosis blocker.
- Stopping lipid peroxidation – Omega-3 balancing and herbal antioxidants prevent fats in the retina from turning rancid.
- Protecting retinal cells – Herbal flavonoids stabilize membranes against iron-induced stress.
- Whole-body balance – Herbal detox approaches may reduce systemic iron overload, lowering risk of ferroptosis in eye tissue.

PATIENT FINANCING

Special Financing with CareCredit
Netra proudly accepts the CareCredit credit card to help you finance your healthcare needs. Now you can can pay with CareCredit and choose from special financing options that may not be available with other credit cards.
Deferred Interest or NO Interest!
- Choose either 6, 12, and 18 months of No Interest Financing!
Balance to be paid in full within the promotional period, else accrued interest is added to existing current promotional balance. - Or Choose Fixed Monthly Payment with Reduced APR Promotional Financing Plans
Your choice of 24, 36, or 48 month terms. (Minimum purchase amount does apply)
*Subject to credit approval.
VIDEO TESTIMONIALS
We invite you to explore the inspiring success stories of our past patients who have experienced remarkable improvements with our treatments.
These real-life success stories highlight how Netra Eye Institute has helped individuals improve their vision, regain confidence, and enhance their quality of life.
These real-life success stories highlight how Netra Eye Institute has helped individuals improve their vision, regain confidence, and enhance their quality of life.
Glaucoma & High Myopia -Vision Improved
Maria
Keratoconus and Myopia - Vision Restored
Veeral
Retinitis Pigmentosa - VISION IMPROVED
Barry
Retinitis Pigmentosa - VISION IMPROVED
Sid
Keratoconus - Advanced Stage
David
GLAUCOMA VISION LOSS IMPROVED
Martin
OPTIC NEURITIS - VISION IMPROVED
Gentry
DIABETIC RETINOPATHY & MACULAR EDEMA
Richard
Retinitis Pigmentosa – Vision Improved
Vani
Optic NERVE Atrophy - VISION IMPROVED
Jennifer
Wet ARMD with CNV - VISION IMPROVED
Pam
MACULAR DEGENERATION VISION IMPROVED*
Nicholas
Improved Vision and IOP from Glaucoma
Sarang
Appointments/Inquiries
FAQ
Discover answers to all your questions and learn how we help save your sight.
Where is Netra Eye Institute located, and are there any branch offices available?
01
Netra Eye Institute is located in South Plainfield, NJ. Currently, there are no branch offices available.
What is the success rate of Netra Restoration Therapy?
02
Netra Restoration Therapy has a very high success rate. For most conditions, patients begin to notice marked improvement in their vision within 7 days of treatment. We are so confident in our treatment results that we offer a money-back guarantee for most patients.
Do you accept my health insurance for the eye treatments?
03
Netra Restoration Therapy (NTR) is a holistic therapy which uses Traditional Chinese Medicine (TCM) consisting of acupuncture and herbal supplements. Holistic therapies such as acupuncture and herbal medicines to treat eye conditions are not covered by your health insurance.
Why Netra Restoration Therapy is not covered by my insurance?
04
Netra Restoration Therapy (NTR) is a holistic therapy which uses Traditional Chinese Medicine (TCM) consisting of acupuncture and herbal supplements. Holistic therapies such as acupuncture and herbal medicines to treat eye conditions are not covered by your health insurance.
Why is my eye doctor not aware of Netra Eye Institute and Netra Restoration Therapy?
05
Your eye doctor may not be aware of Netra and its holistic eye treatments but should be aware on why Vascular Dysregulation, Neurotrophin Deprivation, Neuroprotection, Cytokine Dysregulation, Ocular Inflammation, Oxidative Stress and Ferroptosis causes vision loss.
Multiple recent research have shown these factors leads to most eye disorders.
If they are not aware of these factors you may need to bridge the gap, by providing your doctor with the research articles given under our References section.
Multiple recent research have shown these factors leads to most eye disorders.
If they are not aware of these factors you may need to bridge the gap, by providing your doctor with the research articles given under our References section.
How long are the treatments?
06
The duration of treatment might vary from 2 to 4 weeks depending on the condition treated and its severity.
Degenerative eye conditions might need followup treatments.
Degenerative eye conditions might need followup treatments.
What eye conditons do you treat?
07
Please see our conditions treated section to see the complete list of eye disorders we treat.
Do you offer treatment for children with vision problems?
08
Yes. Most sought condition in children is myopia (nearsightedness) and Keratoconus. Netra Restoration Therapy helps stop progression and impove vision.
Do I have to come in in-person for treatments?
09
Yes. we do not offer remote treatments. Patients have to come in to our office for treatments.
Can I use my HSA, FSA or HRA for payments.
10
Yes. Acupuncture is an eligible expense with a flexible spending account (FSA), health savings account (HSA) or health reimbursement arrangement (HRA).
CONTACT US
READY TO RESTORE YOUR VISION ?
Give us a call at
(732) 503 9999
or fill out the form below.
We’ll get back to you at the earliest, usually within 24 hours.
Oops! Something went wrong while submitting the form.






